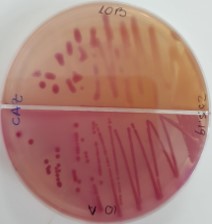
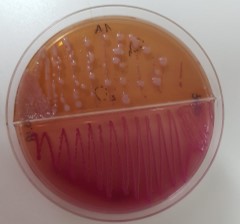

Veterinaria investigadora del Núcleo Milenio MICROB-R y de la Facultad de Ciencias de la Vida de la Universidad Andrés Bello
Uno de los elementos cruciales para Adell es la inocuidad alimentaria en los procesos productivos. En este sentido asegura que el agua puede ser un factor contaminante de los cultivos.
“Si se riega con agua que viene contaminada con patógenos y esta tiene contacto con el alimento, parte de estos patógenos van a quedar en los alimentos. Si estos alimentos son consumidos crudos y sin ser lavados adecuadamente, pueden causar enfermedades en el consumidor”.

¿Cuáles son las enfermedades que los humanos pueden contraer por consumir alimentos con problemas de inocuidad alimentaria?¿Qué importancia reviste para la salud pública asegurar la inocuidad alimentaria en los procesos productivos?
Pueden adquirir cualquier enfermedad que se clasifique dentro de las enfermedades transmisibles por alimentos o ETAs, que son muchas. Algunos de los patógenos que causan estas enfermedades son Escherichia coli productor de toxina Shiga (STEC), Listeria monocitogenes, Salmonella, Norovirus, Campylobacter, Clostridium botulinum que causa el botulismo, entre otros.
Todas estas enfermedades se encuentran en Chile y han causado brotes en nuestro país, como el brote de Norovirus en la región de Antofagasta durante el año 2010 donde se reportaron cerca de 31.000 casos notificados por el ISP, cuya causa fue el consumo de hortalizas crudas contaminadas con aguas servidas cuyo tratamiento presentó una baja concentración de cloro residual.

Otro ejemplo es el brote de cólera del 2018 en la Región Metropolitana que fue asociado a que vegetales estuvieron en contacto con aguas de regadío contaminadas por la bacteria Vibrio cholerae no toxigénico.
En Chile, de acuerdo con el Reglamento sobre Notificación de Enfermedades Transmisibles de Declaración Obligatoria (Decreto Supremo N° 158 / 2004 del Ministerio de Salud, publicado en el Diario Oficial el 10 de mayo de 2005), los brotes de ETA son de notificación obligatoria, con el propósito de constituir un sistema de información que apoye las acciones de salud pública en la prevención y control de estas enfermedades.
En Chile existe un sistema automatizado de vigilancia de ETA dependiente del Departamento de Estadísticas e Información de Salud (DEIS) del Ministerio de Salud (MINSAL).
¿Qué importancia reviste para la salud pública asegurar la inocuidad alimentaria en los procesos productivos?
Tanto en el agua como en los procesos productivos es muy importante asegurar la inocuidad alimentaria ya que, si hay patógenos en cualquier parte del proceso productivo, esta puede llegar a los consumidores y causar enfermedades.
De hecho, múltiples brotes relacionados a alimentos han ocurrido en el mundo, en los cuales una cantidad de personas han enfermado y donde en algunos de ellos, lamentablemente se han producido fallecimientos. Un ejemplo es el brote que ocurrió en Estados Unidos durante el 2019, donde lechugas romaine contaminadas con la bacteria Escherichia coli productora de toxina Shiga (STEC), provocó un brote en el cual se reportaron 167 casos de enfermedad con 85 hospitalizaciones en 17 estados del país.
El Centers for Disease Control (CDC) de EEUU que investigó el caso, sospecha que el agua de riego de las lechugas está implicada en el origen de la contaminación, ya que se encontró la misma cepa de la bacteria en los sedimentos donde se almacenaba el agua de riego.
Otros brotes se asocian a plantas de procesamiento, como los relacionados a brotes con la bacteria Listeria monocytogenes, la cual produce la enfermedad listeriosis, que puede ser fatal y provocar abortos en mujeres embarazadas.

Esta bacteria se caracteriza por crecer en ambientes húmedos, sobrevive e incluso puede multiplicarse a bajas temperaturas, y es muy persistente en plantas de procesamiento de alimentos, ya que forma biopelículas.
Si en una planta productiva no se realizan medidas de sanitización, no se consideran buenas prácticas en sus operaciones ni una prevención adecuada, estas bacterias pueden contaminar los alimentos y causar brotes en los consumidores.
Las plantas de procesamiento de alimentos tienen protocolos rigurosos de desinfección, limpieza, prevención y buenas prácticas en sus operaciones, además de ser constantemente fiscalizadas para que no se produzcan brotes de enfermedad por el consumo de los alimentos que se procesan en dichas plantas.
De todas maneras, se recomienda siempre lavar las verduras en casa antes de consumirlas, aunque vengan envasadas y se indique en el envase que las verduras ya vienen lavadas.
¿Cómo es la calidad del agua de regadío en nuestro país, tomando como referencia los estudios que han realizado?
En nuestro país, la calidad biológica del agua de ríos y canales de irrigación está regulada por la Norma Chilena 1.333 y Decreto Nº 1.775 del Ministerio de Salud, donde se exige un máximo de 1.000 UFC de coliformes fecales/ 100 ml en al menos 5 muestras de un lapso de 2 meses durante la época de riego.
Cabe mencionar, que nuestra norma requiere ser modernizada ya que aún utiliza a los coliformes fecales como indicador de contaminación fecal.

Numerosos estudios científicos a nivel mundial ya han reportado que los coliformes fecales no son buenos indicadores de contaminación fecal en las aguas ya que su ausencia no está correlacionada con ausencia de patógenos (microorganismos que causan enfermedad); además algunos coliformes fecales no son exclusivos del tracto gastrointestinal de animales y hombres, sino que pueden encontrarse en otras fuentes como celulosa, madera, entre otras; y porque los coliformes fecales al ser un grupo de bacterias, no pueden representar virus, parásitos y toda la gama de bacterias que existen y que pueden transmitirse por el agua.
¿Qué tipo de patógenos se pueden encontrar en el agua y que pueden perjudicar la salud humana?

Son numerosos los patógenos que se pueden transmitir por agua y causar enfermedades a las personas. Hay parásitos como Cryptosporidum, Giardia, Toxoplasma gondii, entre otros; bacterias como Salmonella, Vibrio, Listeria, etc; y virus como Norivirus, hepatitis A, etc. Todos estos patógenos recién mencionados, y muchos más que se encuentran en el agua, pueden ser transmitidos a los alimentos y causar enfermedades en humanos.
MICROB-R
¿Cuál es tu rol y líneas de investigación actuales en el Núcleo Milenio MICROB-R?
Mi rol en el Núcleo Milenio MICROB-R es de investigadora joven, y mi responsabilidad es liderar y llevar a cabo las investigaciones que involucran detectar bacterias resistentes en agua de río y afluentes y efluentes de plantas de tratamiento.
Mi línea de investigación es en relación a la calidad biológica del agua, incluyendo la transmisión de patógenos y resistencia antimicrobiana entre humanos, animales y el ambiente. Mis investigaciones abarcan la aplicación de microbiología, estadística, análisis de riesgo, epidemiología avanzada, sustentabilidad y el concepto de “One Health” o “Una Salud”, en el cual se abordan las problemáticas de salud humana, animal y ambiental en un trabajo multidisciplinario con agrónomos, médicos humanos, biólogos, bioquímicos, entre otras disciplinas.
Mis responsabilidades junto con las de mi equipo van, desde hacer un diseño de toma de muestras adecuado, hasta analizar los datos luego del procesamiento de las muestras en el laboratorio; con el fin de detectar la presencia de bacterias en las aguas, determinar su perfil de resistencia y la especie de la bacteria identificada, determinar los factores ambientales que están asociados a su presencia en las aguas y comparar las bacterias encontradas con aquellas encontradas en alimentos y humanos. Todo esto lo hacemos en conjunto con todos los miembros de nuestro núcleo.
¿Por qué crees que es importante el trabajo que están realizando en torno a la resistencia antimicrobiana para la salud pública?
Nuestra investigación es muy importante puesto que la resistencia antimicrobiana ya está causando enfermedades en personas que no están respondiendo a los tratamientos. De hecho, la Organización Mundial de la Salud (OMS) ha indicado que “si no se toman acciones contra el problema de la resistencia antimicrobiana, se estima que las enfermedades resistentes a antibióticos podrían causar hasta 10 millones de muertes cada año para el 2050”. En dicho reporte, la OMS también indica que “actualmente, al menos 700.000 personas mueren por enfermedades que son resistentes a los antimicrobianos”.
En las investigaciones que mis colaboradores y yo hemos llevado a cabo en diversos ríos y canales de irrigación localizados en la zona central de nuestro país, hemos encontrado la presencia de bacterias patógenas (que causan enfermedades en el humano) y bacterias ambientales que son resistentes a antibióticos; incluso en algunos casos hemos aislado bacterias que son resistentes a antibióticos de última generación como lo son los carbapenémicos.
La presencia de bacterias y genes resistentes a antimicrobianos, e incluso a metales pesados como cobre, etc., se han reportado en numerosas investigaciones científicas que se han realizado en distintas partes del mundo. A pesar de que estas bacterias resistentes se han detectado en aguas superficiales (ríos, canales de irrigación, lagos, etc.), aún no se entiende bien cuál es el rol que tiene el agua en la transmisión de estos patógenos a las personas.
Es muy importante definir cuál es el rol que tiene el agua de ríos en la transmisión de bacterias resistentes, para poder crear las medidas de mitigación correspondientes y reducir el riesgo para la salud de las personas.
Que es una investigación donde se aplica el enfoque “Una Salud”. ¿Y cómo MICROB-R aborda este concepto en la práctica?
El núcleo MICROB-R aborda la resistencia antimicrobiana considerando la simultaneidad de factores en este fenómeno, para lo cual toma en consideración los componentes de salud humana, salud animal y salud medio ambiental; ya que los problemas surgen cuando alguno de los tres componentes presenta algún desbalance.
Este concepto requiere de trabajo multidisciplinario, por lo que nuestro núcleo está conformado por investigadores de diversas disciplinas: médicos humanos, médicos veterinarios, biólogos, microbiólogos, abogados, entre otros. Por ejemplo, participamos en un proyecto llamado MAUCO, en la Región del Maule, donde abordamos los tres componentes de salud de manera simultánea. Este proyecto es un estudio de cohorte con una duración de 10 años, con una población objetivo de 10 mil vecinos, que busca comprender qué factores influyen o previenen el desarrollo de las principales enfermedades crónicas que afectan a nuestra población: enfermedades cardiovasculares, diabetes, obesidad, enfermedades respiratorias, demencia y cáncer.
En MICROB-R el componente de salud humano es liderado por el médico infectólogo humano Dr. José Munita de la Universidad del Desarrollo; el componente de salud animal está siendo liderado por el Dr. Julio Benavides y la Dra. Pamela Thomson, ambos de la Universidad Andrés Bello; mientras que el componente ambiental es liderado por el Dr. Jorge Olivares (Pontificia Universidad Católica de Valparaíso) y yo, y el de alimentos lo encabeza la Dra. Andrea Moreno (Pontificia Universidad Católica de Chile).
El hecho que MICROB-R esté investigando la problemática de resistencia antimicrobiana utilizando un enfoque de “One Health”, permitirá obtener respuestas que nos ayudarán a entender más el fenómeno de la resistencia y proponer medidas de control y prevención adecuadas.
¿De qué forma impactan la sequía presente actualmente y el cambio climático en la calidad del agua para producir alimentos?
El cambio climático se ha presentado de múltiples formas, incluyendo aumento en la frecuencia de lluvias en algunas zonas; aumento de temperatura e inundaciones; y en otras zonas se presenta con sequías. En Chile el cambio climático se ha presentado con lluvias que ocurren sobre la isoterma, con la conducente a aluviones de barro y desprendimiento de montañas, como se ha visto en el Cajón del Maipo en los últimos años y en la zona norte de país, con devastadores efectos.
Esto conlleva a que la inocuidad de agua potable y de irrigación se vea fuertemente deteriorada, incluso estos eventos causaron cortes de agua potable que duraron varios días generando el descontento de la población. Además, se han reportado numerosos episodios de contaminación del agua, que siguieron a inundaciones; específicamente a través de la contaminación de fuentes subterráneas de agua potable y al deterioro de las aguas superficiales.
La sequía además tiene el efecto de aumentar la concentración de patógenos que hay en el agua, ya que el material fecal y patógenos que son regularmente vertidos en fuentes de agua, en condiciones de sequía, van a ser vertidos en una fuente que lleva menos volumen de agua de lo habitual. Por ende, hay un menor efecto de dilución por parte del río o fuente de agua, causando que se detecten más patógenos por milímetro de agua.
¿Cómo han trabajado y conversado con el mundo productivo para incorporar ciencia en los procesos de inocuidad alimentaria?
Personalmente y junto a la Dra. Andrea Moreno hemos sido invitadas a varios eventos organizados por empresas y organizaciones como 3M, Biomeriux, ILSI e Inofood, entre otras; para dar charlas y capacitaciones en inocuidad alimentaria a personal de empresas relacionadas a la producción de alimentos.
Además, hemos tenido reuniones con empresas que producen alimentos, e incluso los exportan; para poder colaborar e incorporar ciencia a los procesos productivos para asegurar la inocuidad alimentaria. También hemos trabajado con pequeños y medianos productores agrícolas.
¿Cuáles son los desafíos de mediano y largo plazo en materia de inocuidad alimentaria?
Los desafíos a mediano y largo plazo son muchos. Uno de los pasos más importantes es que la industria, el sector público y las universidades trabajen juntas para resolver estos temas de inocuidad de agua y de alimentos.
La Agencia Chilena para la Inocuidad y Calidad Alimentaria (ACHIPIA) está intentando que eso sea posible. Lo que ocurre actualmente es que el sector privado relacionado a producción de alimentos, no es muy abierto a que investigadores de universidades realicen investigaciones en sus industrias. Existe la preocupación que se genere miedo en la población y afecte las ventas, si es que se encuentra algún patógeno dentro de sus plantas, además de recibir posibles multas por parte del sector privado.
Es muy importante capacitar y educar a los productores con respecto a qué es la inocuidad alimentaria y enfatizar que se realicen buenas prácticas y manejo, sobre todo del agua, en sus predios.
Otro desafío, a largo plazo, es modificar las normativas de agua superficial y de irrigación de nuestro país, para reemplazar los actuales coliformes fecales por mejores indicadores. También se requiere mejorar y aumentar la fiscalización de aquellas fuentes contaminantes de nuestras aguas, y que se generen multas o las medidas adecuadas.
¿Y hay consideraciones que involucren al consumidor final?
Otro desafío de mediano y largo plazo en inocuidad, es que hay que realzar la educación y conciencia del consumidor final, en relación a cómo procesa, manipula y prepara los alimentos.
Algunas medidas concretas y simples que se pueden aplicar en casa son: utilizar agua potable para lavar alimentos, sobre todo verduras u otros que se consumen crudas; utilizar insumos de cocina diferenciados para carnes y vegetales, como cuchillos y tablas; mantener la cadena de frío en alimentos de rápida descomposición o de riesgo de multiplicación bacteriana, como mariscos, pescados, carnes, quesos frescos, e incluso pulpas de jugos o smoothies; verificar constantemente cuánto tiempo lleva un producto en el refrigerador, y eliminar aquellos que llevan mucho tiempo; y verificar la fecha de vencimiento de los productos; entre otras precauciones.
Formación y experiencia
¿Cuál es tu formación académica y experiencia profesional?
Soy Médico Veterinario de la Universidad Mayor, título que obtuve el año 2006. Gracias a la adjudicación de la Beca Presidente de la República, pude realizar estudios de posgrado en el extranjero. Un Magíster en Medicina Veterinaria Preventiva, que obtuve el año 2009, y un PhD en Patología Comparada, en el 2013, ambos en la Universidad de California, en Davis, Estados Unidos,.
Con respecto a mi experiencia laboral, desde el 2014 hasta la fecha soy profesora asistente, en jornada completa, en la Universidad Andrés Bello. Mis funciones consisten en realizar docencia de pre y posgrado, investigación, gestión, internacionalización y vinculación con el medio.
¿Por qué optaste por estudiar y desarrollarte profesionalmente en temas ligados a investigación científica?
Siempre me gustó la biología y el trabajo de laboratorio, pero me di cuenta que era a esto a lo que me quería dedicar, cuando asistí a la cátedra de epidemiología y salud pública, en quinto año de Medicina Veterinaria y donde hice mi tesis en investigación.